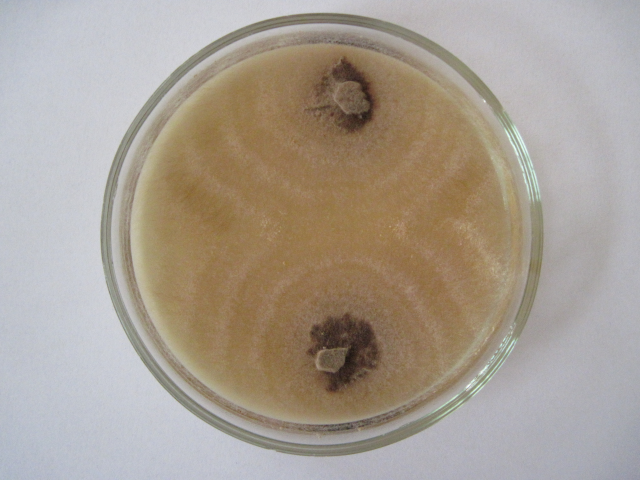

Досліджуємо збудника ризоктоніозу – гриба Rhizoctonia solani.
Картопля належить до найважливіших сільськогосподарських культур. Вона має різнобічне використання. Це винятково важливий продукт харчування. Недарма її називають «другим хлібом». Щорічно в Україні вирощується в середньому 19,5 млн тон картоплі, середня врожайність коливається в межах 16-20 т/га.

Небезпечною хворобою картоплі є ризоктоніоз (чорна парша), яку викликає гриб Thanatephorus cucumeris (Frank) Donk (Rhizoctonia solani Kühn.) Захворювання призводить до зниження 40-60 % врожаю, погіршення товарності бульб.

Важливим заходом контролю розвитку хвороби є вчасна її діагностика та знання різних аспектів біоекології патогену. Тому під егідою студентського наукового гуртка (керівник – доцент кафедри фітопатології ім. акад. В.Ф. Пересипкіна, доктор с.-г. наук Піковський М.Й.), на базі проблемної науково-дослідної лабораторії Мікології та фітопатології, Назар Тарнавський і Руслан Круковський провели обстеження уражених зразків картоплі та ізоляцію фітопатогену у чисту культуру. Надалі будуть виконуватися дослідження екологічних особливостей гриба R. solani.
Назар Тарнавський